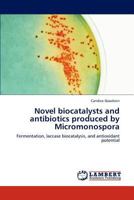
Novel biocatalysts and antibiotics produced by Micromonospora 3845475781 Book Cover

Enter Entropy: Volume 2
$29.51

Enter Entropy (Volume One)
Out of Stock

Enter Entropy: Volume Three
$29.51
Novel biocatalysts and antibiotics produced by Micromonospora
Out of Stock

Enter Entropy
$29.27

Cand!ce Keeps Happening
$17.37

Earth2Candice (Cand!ce Keeps Happening and Earth2Candice)
$15.80

Entangled Pairs
$24.99